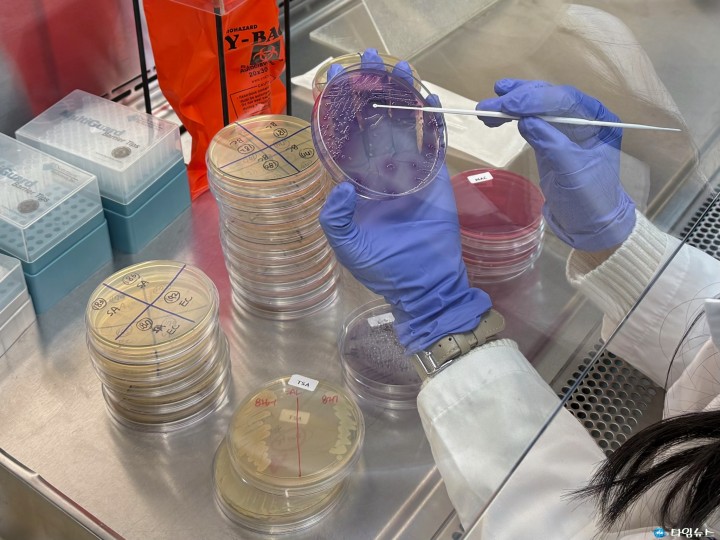

[충북보환연, 도내 학교급식 안전성 검사 결과 ‘모두 적합’]
충북 초·중·고 학교급식 ‘안심’… 식중독 원인균 전수 검사 결과 모두 ‘적합’
[충북타임뉴스=한정순 기자] 충북도내 초·중·고 학생들의 급식이 올해도 안전한 것으로 확인됐다. 충북보건환경연구원(원장 임헌표)은 4월부터 11월까지 도 교육청과 함께 도내 42개 학교 집단급식시설을 대상으로 급식 안전성 검사를 실시한 결과, 모든 검체가 법적 기준에 ‘적합’ 판정을 받았다고 3일 밝혔다.
 이번 조사는 조리식품과 조리기구, 조리실 환경 표면 등 식중독 집단 발생 가능성이 높은 급식시설 전반을 선제 점검하기 위한 것으로, 총 168건의 검체를 대상으로 살모넬라·황색포도상구균·대장균 등 주요 식중독 원인균 3종을 검사한 결과 전부 ‘불검출’로 확인됐다.
이번 조사는 조리식품과 조리기구, 조리실 환경 표면 등 식중독 집단 발생 가능성이 높은 급식시설 전반을 선제 점검하기 위한 것으로, 총 168건의 검체를 대상으로 살모넬라·황색포도상구균·대장균 등 주요 식중독 원인균 3종을 검사한 결과 전부 ‘불검출’로 확인됐다.
 여기에 더해 보존식 용기, 배식대, 배식용 앞치마 등 환경 검체 126건에 대해 그룹A형로타바이러스, 아스트로바이러스, 장내아데노바이러스, 노로바이러스, 사포바이러스 등 식중독 바이러스 5종을 추가 검사한 결과 역시 모두 불검출로 나타났다.
여기에 더해 보존식 용기, 배식대, 배식용 앞치마 등 환경 검체 126건에 대해 그룹A형로타바이러스, 아스트로바이러스, 장내아데노바이러스, 노로바이러스, 사포바이러스 등 식중독 바이러스 5종을 추가 검사한 결과 역시 모두 불검출로 나타났다.
충북보건환경연구원 윤방한 미생물과장은 “집단 식중독을 원천 차단하고 학생과 학부모가 안심할 수 있는 급식 환경을 만드는 것이 최우선"이라며 “현장 위생 관리를 지속 강화하고, 급식 안전성 검사를 앞으로 더욱 확대해 나가겠다"고 강조했다. 학생 건강 보호를 위한 철저한 위생검사가 확대되는 가운데, 충북도 학교급식 전반의 안전 수준이 다시 한번 확인되며 학부모들의 불안을 해소하는 계기가 됐다는 평가다.
충북보건환경연구원 윤방한 미생물과장은 “집단 식중독을 원천 차단하고 학생과 학부모가 안심할 수 있는 급식 환경을 만드는 것이 최우선"이라며 “현장 위생 관리를 지속 강화하고, 급식 안전성 검사를 앞으로 더욱 확대해 나가겠다"고 강조했다. 학생 건강 보호를 위한 철저한 위생검사가 확대되는 가운데, 충북도 학교급식 전반의 안전 수준이 다시 한번 확인되며 학부모들의 불안을 해소하는 계기가 됐다는 평가다.
한정순 기자
<저작권자 © 타임뉴스 무단전재 및 재배포 금지>

댓글
댓글 기능은 준비 중입니다.